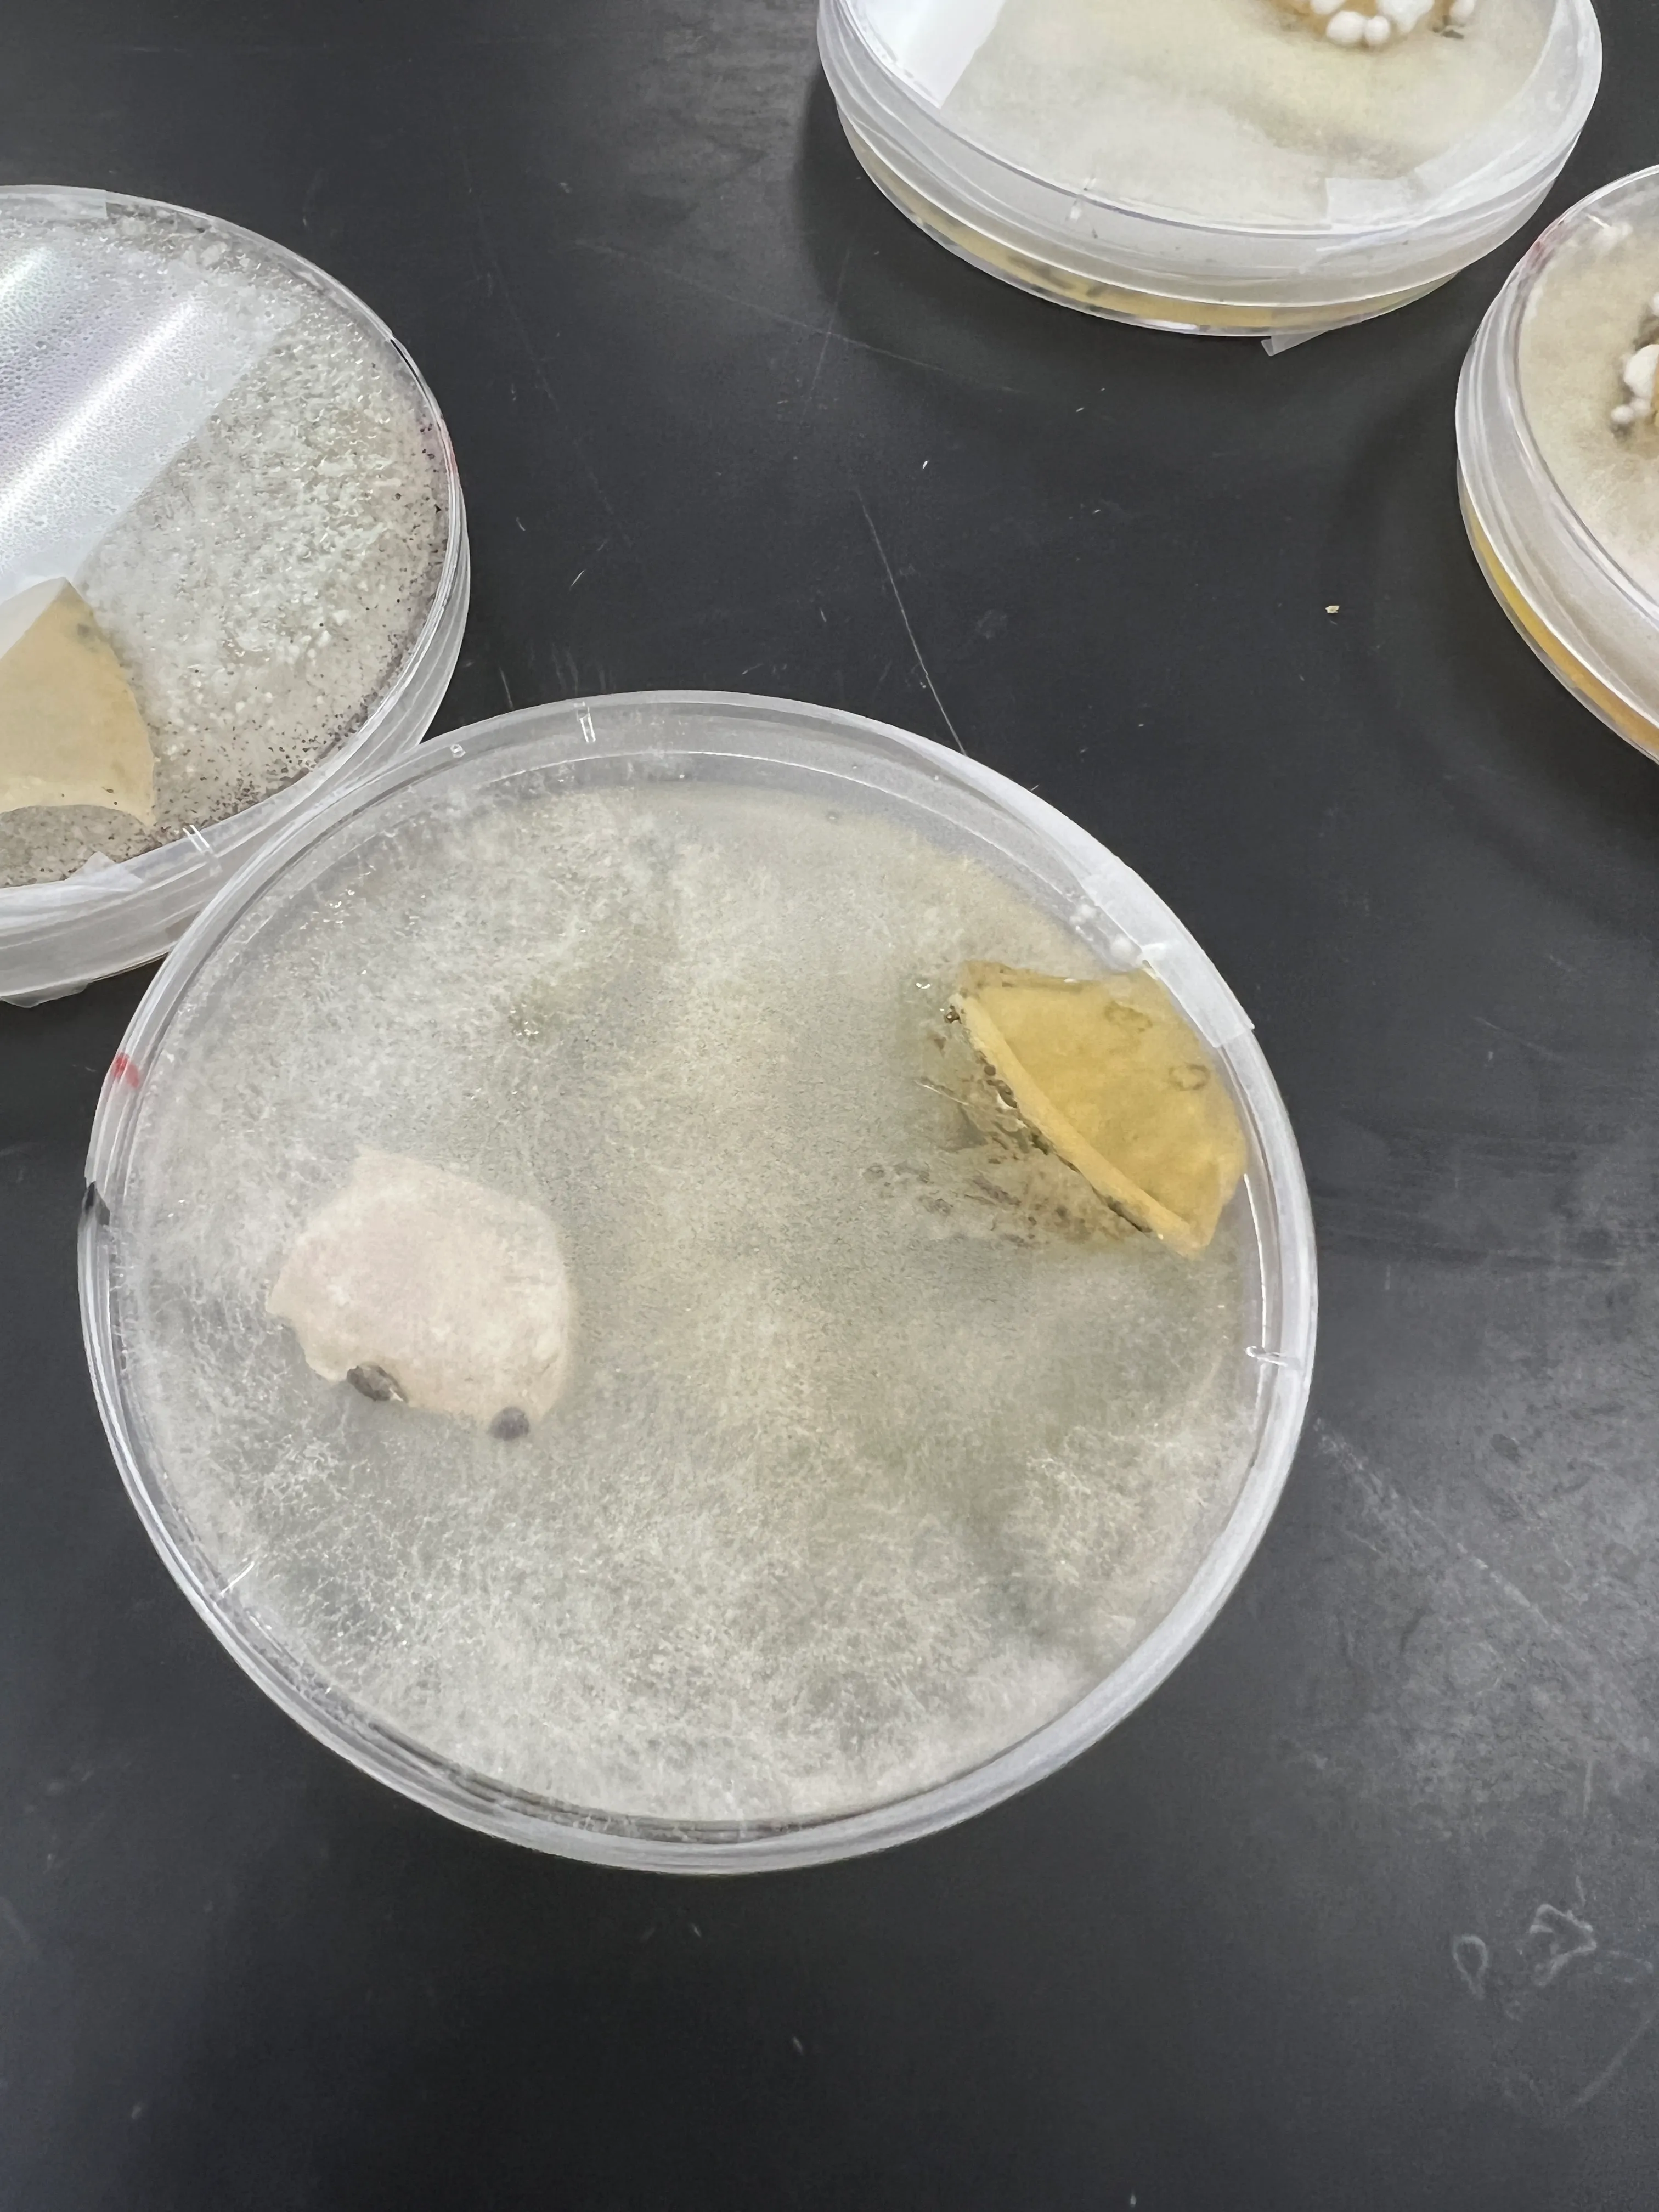
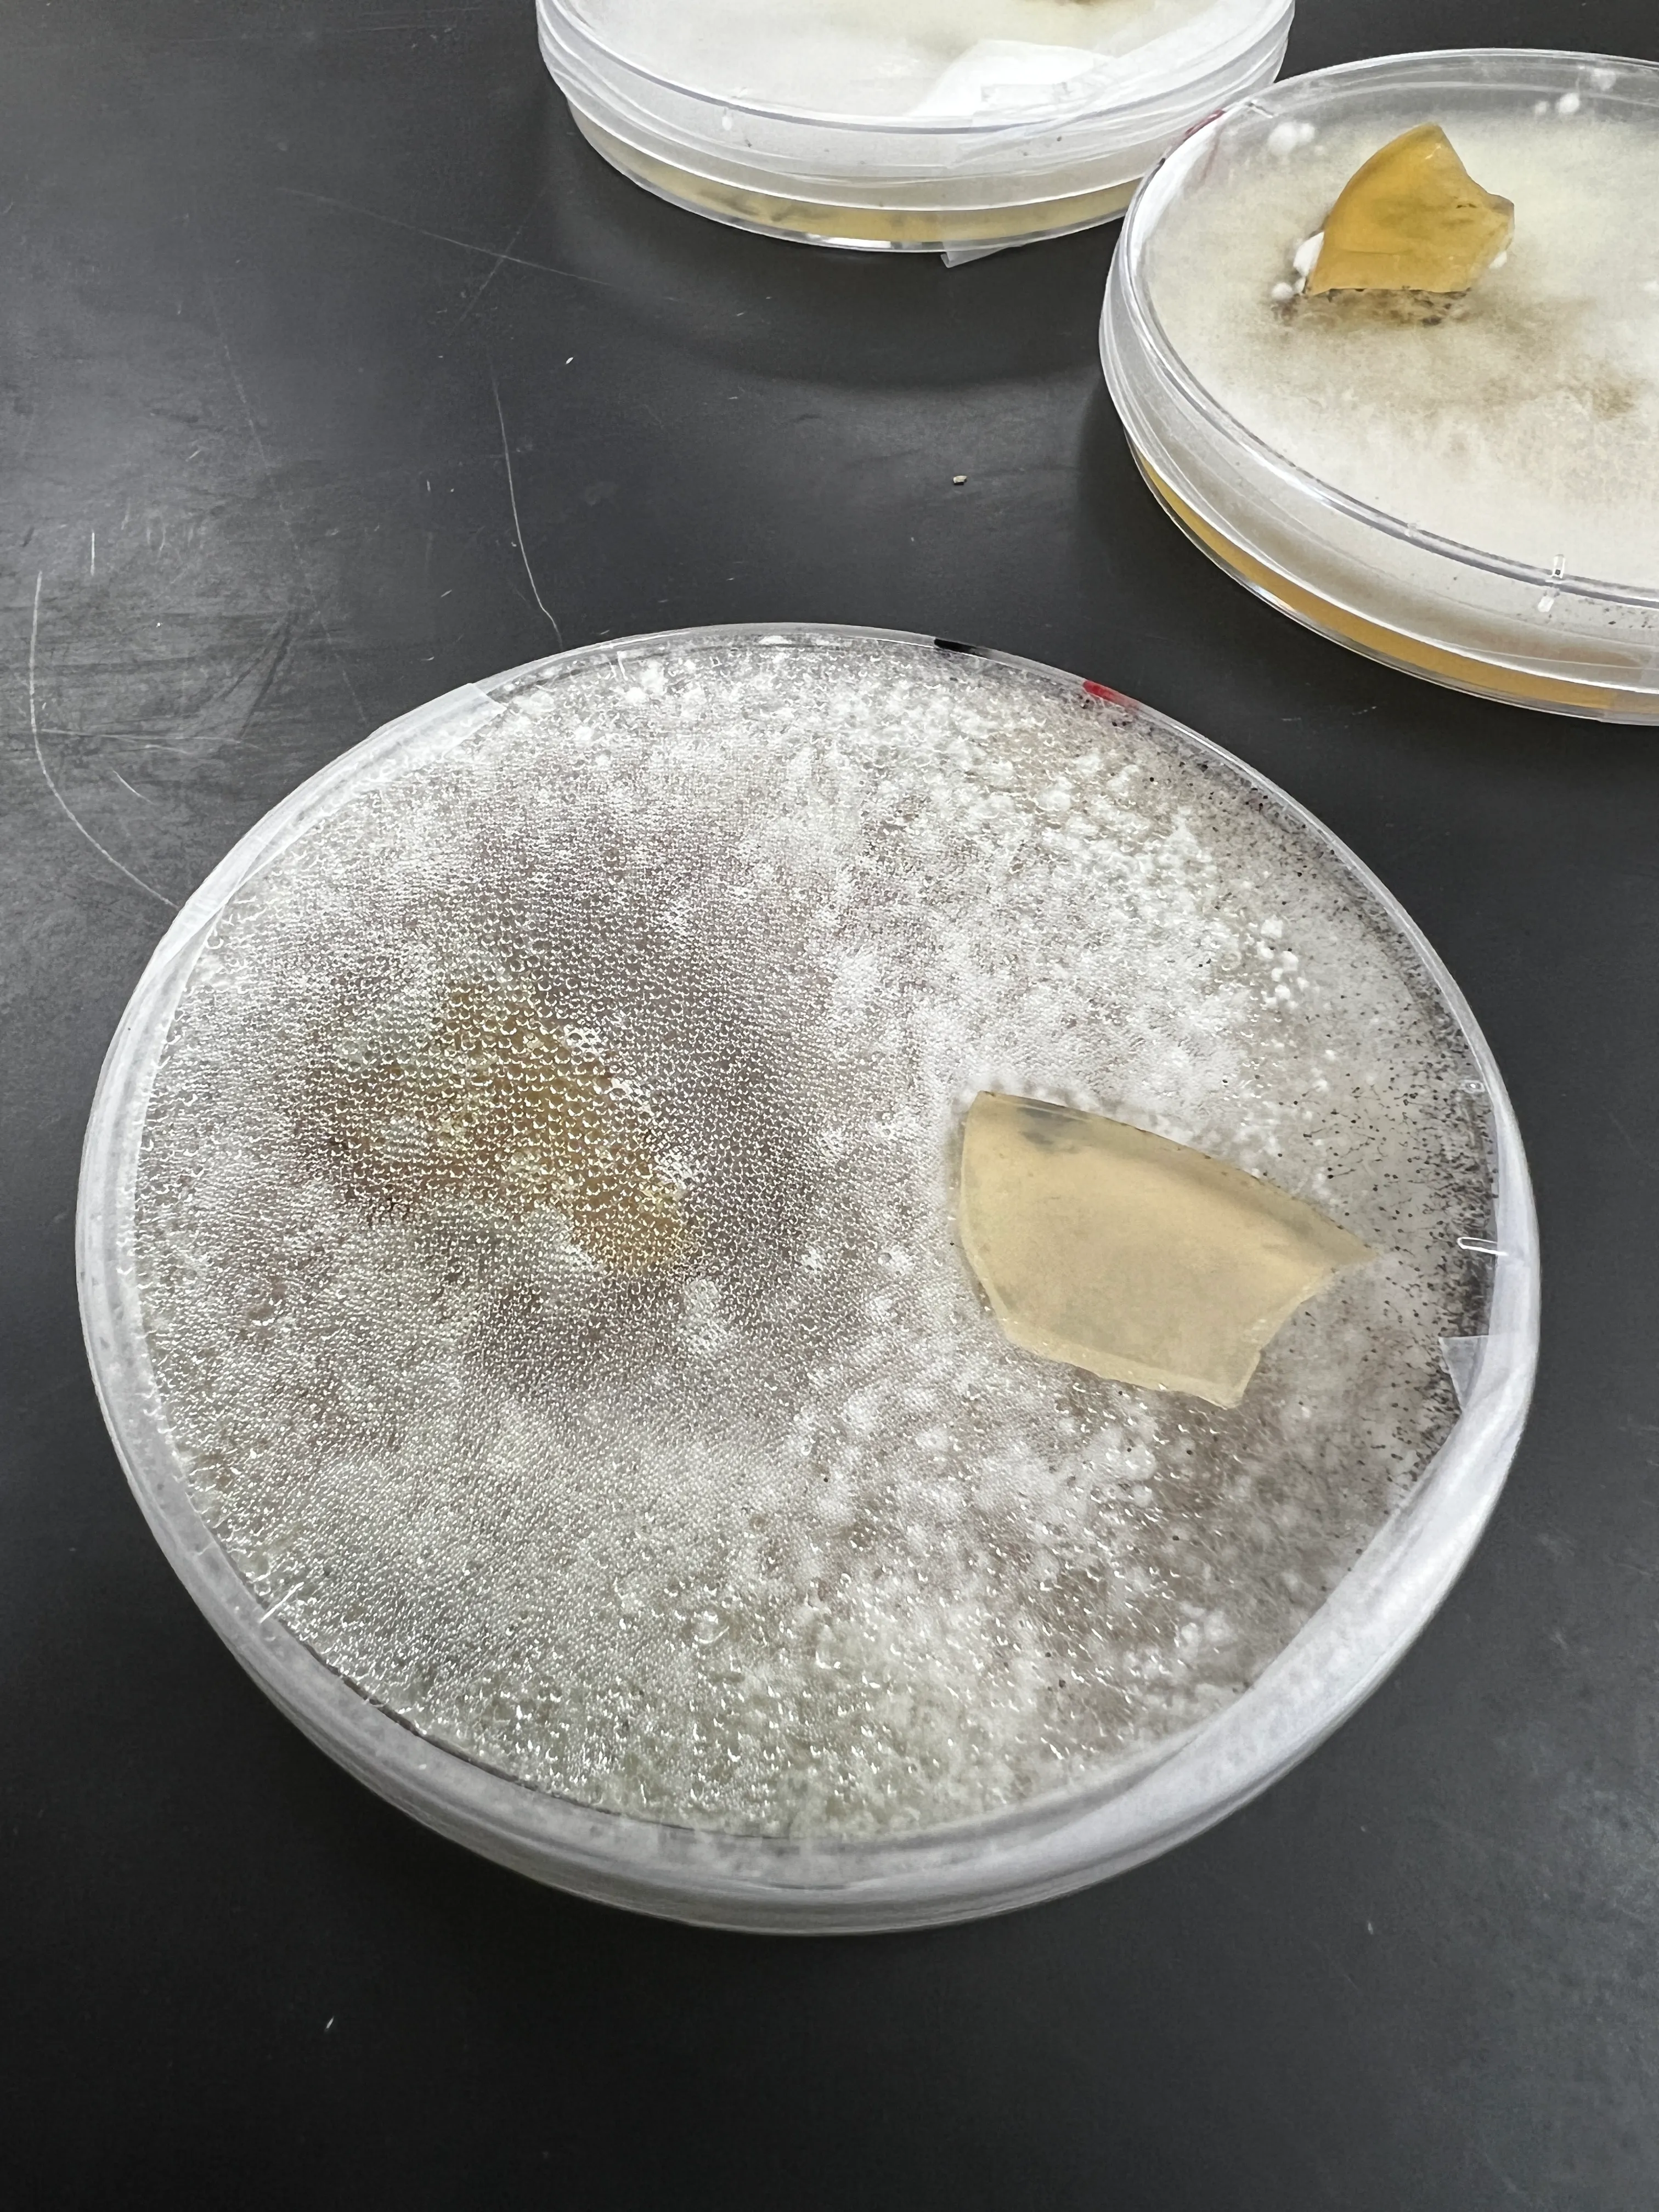

Experiment #2: Growth of Trichoderma harzianum in a Petri dish with Sclerotinia sclerotiorum
Hypothesis: T. harzianum will suppress the growth of white mold inside a Petri dish.
Experiment
Prepare 6 Petri dishes. For this experiment, I used Potato Dextrose Agar (PDA) plates because it was what my lab had available. In four of the dishes, take a sample from a pure culture of Sclerotinia sclerotiorum and place it in the new dishes. In the other two dishes as well as two with S. sclerotiorum, take a sample from a pure culture of Trichoderma harzianum and place it in the new dishes. Do your best to keep the samples around the same area for more consistent results.
Control
For this experiment, I’ll grow two plates with only S. sclerotiorum and another two plates with only T. harzianum.
Treatments
I’ll grow two plates with S. sclerotiorum and T. harzianum together. Later, I can can compare the growth of S. sclerotiorum in the presence of T. harzianum to the growth of S. sclerotiorum and T. harzianum alone.
These plates were left at room temperature (~21 °C) for 6 days.
Results
Upon inspection, there were unexpected growths in the T. harzianum plates. The S. sclerotiorum plates grew normally, but the T. harzianum plates had a lot of contamination. In the plates with both S. sclerotiorum and T. harzianum there were still results to be taken.
The isolated S. sclerotiorum plates
These grew as expected. The S. sclerotiorum plates grew normally, with a lot of white mycelium.
The contaminated T. harzianum plates
These plates had a lot of contamination. I think that the T. harzianum was not able to grow because it was contaminated with other fungi. Redoing this experiment with a more sterile environment would be a good idea.
![]() | ![]() |
In the first plate, there is a noticeable slow of growth of S. sclerotiorum in the presence of T. harzianum. The second plate shows a similar result, but had too much condensation to take a good picture.
Conclusion
Unfortunately, this experiment was not very successful. The T. harzianum plates were contaminated and I was not able to get a good picture of the interaction between S. sclerotiorum and T. harzianum. However, I did see that there was a slow of growth of S. sclerotiorum in the presence of T. harzianum. This is a good sign that T. harzianum is able to fend off the competition, but no where conclusive enough to prove my hypothesis. Going forward, I would like to repeat this experiment with a more sterile environment to get better results. I think fresher T. harzianum would also encourage more rapid growth when plated alone. I would also like to try this experiment with other fungi to see if T. harzianum is able to fend off other competitors.